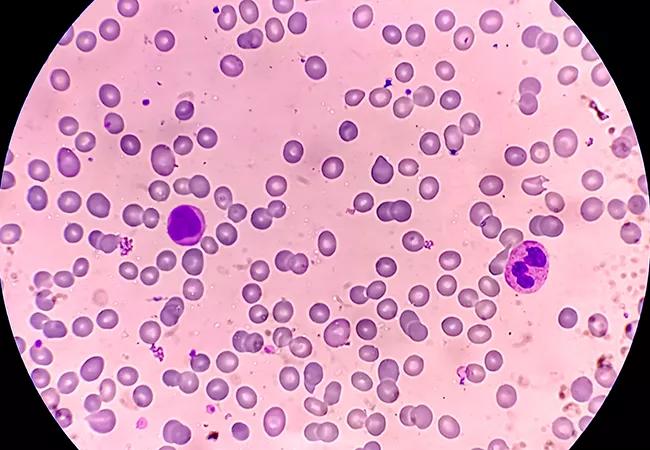

Research aims to find a biomarker for early detection and intervention
Image content: This image is available to view online.
View image online (https://assets.clevelandclinic.org/transform/1b46e119-f5e7-4aa2-b403-0c5a7119837e/650x450-congenital-neutropenia-1356006038_jpg)
650×450-congenital-neutropenia-1356006038
Severe congenital neutropenia (SCN) is a bone marrow failure syndrome that affects approximately 1 in 250,000 live births. The severe deficiency of neutrophils makes children prone to infection. The disease presents in infancy with lung, skin or gut infections.
Advertisement
Cleveland Clinic is a non-profit academic medical center. Advertising on our site helps support our mission. We do not endorse non-Cleveland Clinic products or services. Policy
Most SCN patients are treated with filgrastim (recombinant human granulocyte colony-stimulating factor), which reduces life-threatening infections and has greatly improved prognosis and quality of life. Hematopoietic cell transplantation is used in some cases, including patients who do not tolerate or respond well to filgrastim.
At Cleveland Clinic, SCN patients are treated at the bone marrow failure clinic, which offers comprehensive multidisciplinary care from specialists ranging from genetic counselors to hematologists. “Our aim is to identify each patient’s needs and provide one-stop shopping to efficiently and accurately meet their healthcare needs,” says Seth Corey, MD, MPH, clinic director and a pediatric oncologist at Cleveland Clinic Children’s and a professor in the Department of Pediatric Hematology/Oncology and Cancer Biology at Cleveland Clinic.
A major concern with SCN is the risk of transformation to myelodysplastic syndrome (MDS) and acute myeloid leukemia (AML): Approximately 20% of pediatric patients with SCN develop cancerous conditions of the blood during adolescence and young adulthood. Those who do develop MDS/ AML are more resistant to chemotherapy and have fair survival rates.
SCN is caused by mutations in many different genes, primarily the ELANE gene, which plays a role in the structure and function of neutrophils. About half of all SCN cases have mutations in the ELANE gene that is passed on either from one of the parents or arises early during fetal development.
Advertisement
Currently, little is known about the factors that drive the transformation to MDS or AML because the disease cannot be replicated in mouse models. This is due to differences between humans and mice: The predominant white blood cell in humans is the neutrophil, and in the mouse, the lymphocyte. In addition, humans express multiple forms of CSF3R (receptor for granulocyte colony stimulating factor), while no isoforms have been identified in mice.
Almost all (70%) of the SCN patients who develop MDS/AML acquire truncating mutation in CSF3R. Recurrent nonsense and missense mutations in CSF3R have been found in patients with MDS/AML. “It is challenging to study a rare disease with a decade long latency period before complications arise without having a robust experimental model. The biggest challenge to developing better therapies is the absence of an animal model to study the development of severe congenital neutropenia and evaluate novel interventions,” says Dr. Corey.
Related to their research on Shwachman-Diamond syndrome, which has increased our understanding of the molecular processes that lead to leukemia predisposition, Dr. Corey and his research team, including Hrishikesh Mehta, PhD, in Cancer Biology, are working on creating a new, innovative mouse model that will closely mimic SCN-related leukemia in humans. Using this model, they can test their hypothesis that the multiple forms of CSF3R play a key role in the pathogenesis of SCN. If it proves to be true, they will work to develop additional biomarkers and algorithms to identify patients who are at greatest risk of transformation to MDS/AML and intervene before the resistant cancer cells emerge.
Advertisement
The researchers are also collaborating with other Cleveland Clinic scientists to develop more effective therapies for SCN and Shwachman-Diamond syndrome.
Advertisement
Advertisement
Research reveals low infant risk but ongoing impact on parents
Cleveland Clinic welcomes world-leading chest wall surgeon Dr. Hyung Joo Park
Common misconceptions about perioperative management and strategies to improve care
Life-changing gene therapy is currently under FDA review
How evolving medical therapies and more precise patient selection are reshaping the role of intestinal transplantation
Cleveland Clinic specialist discusses the new clinical practice guideline
Introducing Prajwal Rajappa, MD, MS, Director of Pediatric Precision Oncology
The one-stop THRIVE clinic addresses renal, psychosocial, educational and other challenges alongside cardiac surveillance